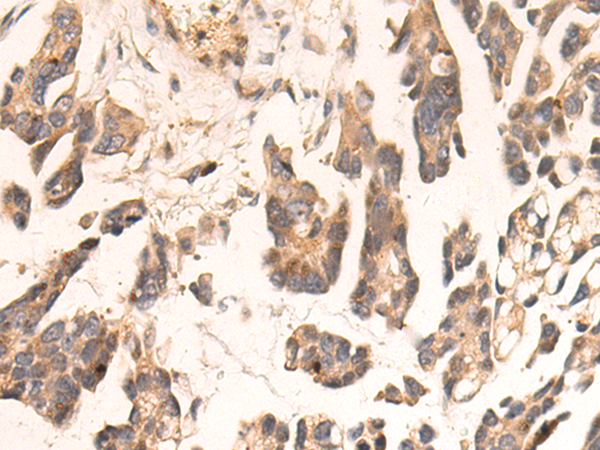

别名:CTLO; HAMSV; HRAS1; RASH1; p21ras; C-H-RAS; H-RASIDX; C-BAS/HAS; C-HA-RAS1应用:WB,IHC
反应种属:Human, Mouse, Rat
规格:50μl/100μl
| Description |
|---|
| This gene belongs to the Ras oncogene family, whose members are related to the transforming genes of mammalian sarcoma retroviruses. The products encoded by these genes function in signal transduction pathways. These proteins can bind GTP and GDP, and they have intrinsic GTPase activity. This protein undergoes a continuous cycle of de- and re-palmitoylation, which regulates its rapid exchange between the plasma membrane and the Golgi apparatus. Mutations in this gene cause Costello syndrome, a disease characterized by increased growth at the prenatal stage, growth deficiency at the postnatal stage, predisposition to tumor formation, cognitive disability, skin and musculoskeletal abnormalities, distinctive facial appearance and cardiovascular abnormalities. Defects in this gene are implicated in a variety of cancers, including bladder cancer, follicular thyroid cancer, and oral squamous cell carcinoma. Multiple transcript variants, which encode different isoforms, have been identified for this gene. |
| Specification | |
|---|---|
| Aliases | CTLO; HAMSV; HRAS1; RASH1; p21ras; C-H-RAS; H-RASIDX; C-BAS/HAS; C-HA-RAS1 |
| Swissprot | P01112 |
| WB Predicted band size | 21 kDa |
| Host/Isotype | Rabbit IgG |
| Storage | Store at 4°C short term. Aliquot and store at -20°C long term. Avoid freeze/thaw cycles. |
| Species Reactivity | Human, Mouse, Rat |
| Immunogen | Synthetic peptide of human HRAS |
| Formulation | pH7.4 PBS, 0.05% NaN3, 40% Glycerol |
| Application | |
|---|---|
| WB | 1/200-1/1000 |
| IHC | 1/50-1/100 |
| ELISA | 1/5000-1/10000 |
![]() |
Gel: 10%SDS-PAGE, Lysate: 40 μg, Lane: Mouse brain tissue lysate, Primary antibody: P06879(HRAS Antibody) at dilution 1/300, Secondary antibody: Goat anti rabbit IgG at 1/5000 dilution, Exposure time: 90 seconds |
![]() |
The image is immunohistochemistry of paraffin-embedded Human colorectal cancer tissue using P06879(HRAS Antibody) at dilution 1/50. (Original magnification: ×200) |
![]() |
The image is immunohistochemistry of paraffin-embedded Human thyroid cancer tissue using P06879(HRAS Antibody) at dilution 1/50. (Original magnification: ×200) |
本公司的所有产品仅用于科学研究或者工业应用等非医疗目的,不可用于人类或动物的临床诊断或治疗,非药用,非食用。
暂无评论
本公司的所有产品仅用于科学研究或者工业应用等非医疗目的,不可用于人类或动物的临床诊断或治疗,非药用,非食用。
中文

发表回复